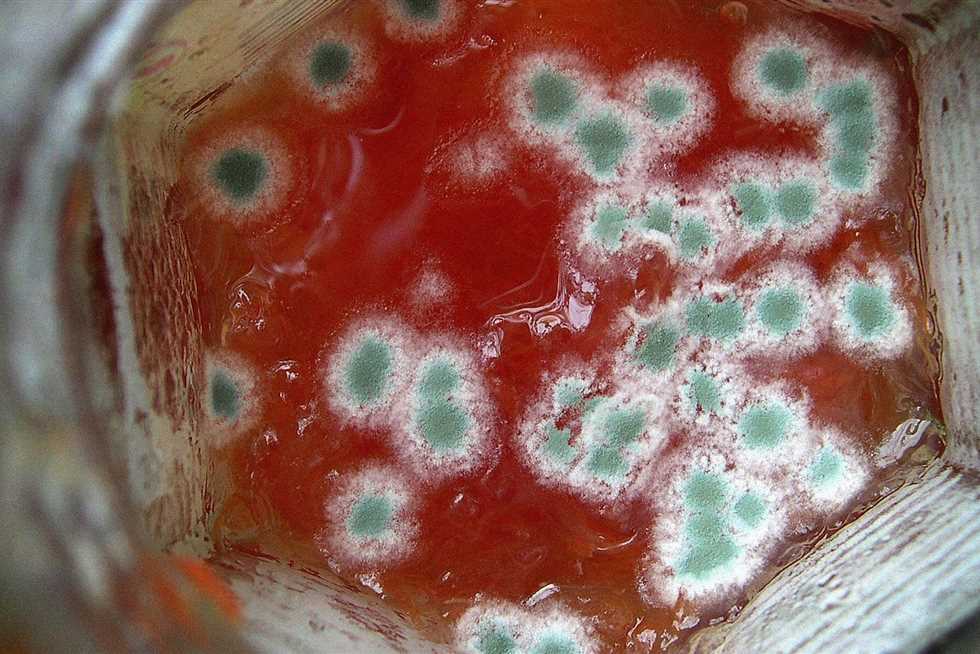
من عفن الطعام إلى السموم.. خطر الميكوتوكسينات في صلصة الطماطم

الآثار الفرعونية مقدسة بالعالم كله.. زاهي حواس يرد على مهاجمي الحضارة المصرية القديمة (فيديو)

 أكد الدكتور زاهي حواس، عالم الآثار، أن المتحف المصري الكبير مشروع ثقافي يفيد العالم كله، ولا يوجد متحف في العالم مثل المتحف المصري الكبير، وقد شاهد افتتاحه العالم كله. وقال خلال لقائه مع الإعلامي أحمد موسى في برنامج "على مسئوليتي" المذاع على قناة "صدى البلد"، إن...
أكد الدكتور زاهي حواس، عالم الآثار، أن المتحف المصري الكبير مشروع ثقافي يفيد العالم كله، ولا يوجد متحف في العالم مثل المتحف المصري الكبير، وقد شاهد افتتاحه العالم كله. وقال خلال لقائه مع الإعلامي أحمد موسى في برنامج "على مسئوليتي" المذاع على قناة "صدى البلد"، إن...